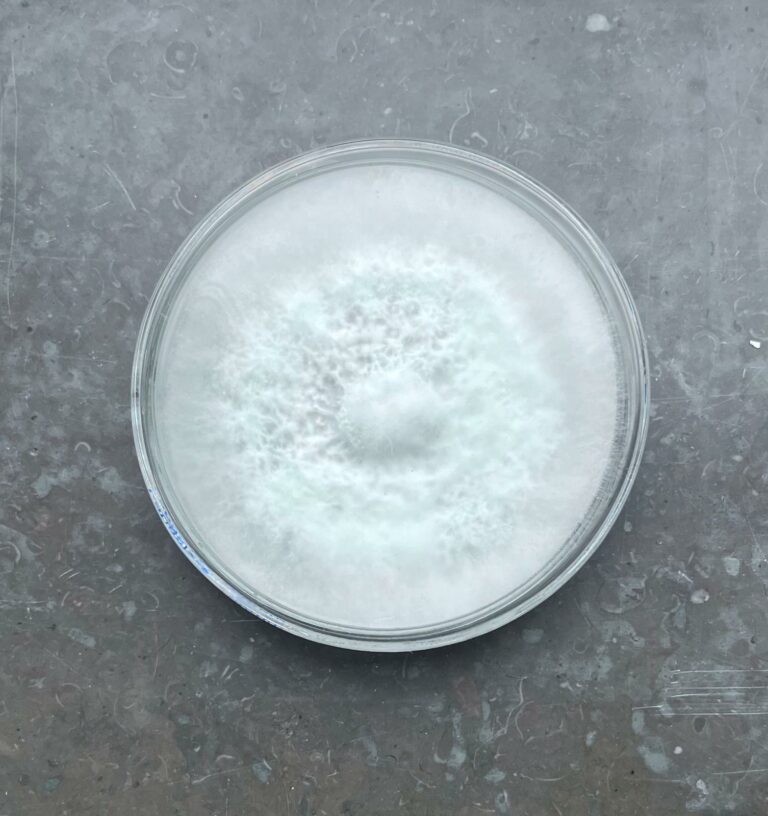

På Mykoteket odlar vi färska, obesprutade svampar mitt i hjärtat av Malmö.
Vårt uppdrag är enkelt: att göra lokal och hållbar matproduktion till en naturlig del av vardagen.
Mykoteket består av Rodrigo (biolog med passion för svampar och odling) och Kajsa (samhällsvetare med fokus på social och miljömässig hållbarhet). Tillsammans förenar vi vetenskap, hantverk och omsorg – från att odla mycelet till att handskörda varje svamp.
Genom att odla lokalt, minska transporter och svinn bidrar vi till ett cirkulärt, transparent och motståndskraftigt matsystem – en svamp i taget 🍄🟫🍀


Det ursprungliga priset var: 300,00 kr.250,00 krDet nuvarande priset är: 250,00 kr.

Det ursprungliga priset var: 70,00 kr.60,00 krDet nuvarande priset är: 60,00 kr.

Det ursprungliga priset var: 105,00 kr.90,00 krDet nuvarande priset är: 90,00 kr.

Det ursprungliga priset var: 140,00 kr.120,00 krDet nuvarande priset är: 120,00 kr.

Det ursprungliga priset var: 175,00 kr.150,00 krDet nuvarande priset är: 150,00 kr.

Det ursprungliga priset var: 35,00 kr.30,00 krDet nuvarande priset är: 30,00 kr.